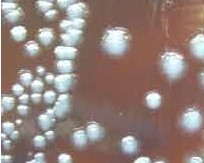

Leeuwenhoek et Pasteur, un dialogue singulier
par Jean Roussaux
Texte support de la conférence de la SHALP faite au Palais de la culture de Puteaux le 4 Mai 2024.
Par un bel après-midi, au paradis des savants, Leeuwenhoek fait sa promenade au parc de la science. Il croise Einstein et Newton en grande conversation,
probablement sur la gravitation universelle. Plus loin, il aperçoit D'Alembert, le mathématicien de l'Encyclopédie, qui chemine l'air rêveur et voilà que
vient à sa rencontre un vieil homme, marchant avec une canne et claudiquant un peu. Leeuwenhoek le reconnait : c'est Pasteur. Il a une furieuse envie d'engager
la conversation. Il l'interpelle.
Bonjour Monsieur Pasteur, belle promenade !
Euh, Ah, oui, bonjour. à qui ai-je l'honneur ?
Leeuwenhoek, Antoni van Leeuwenhoek de Delft.
Leuvenhouk ? Leuvenhouk ? Ah oui ! LeeuwenhOEK ! c'est vous le petit drapier soi-disant inventeur du microscope et soi-disant découvreur des microbes.
C'est cela, Monsieur Pasteur, c'est cela mais le soi-disant est en trop !!
Le dialogue est mal engagé.
Vous avez bien de la chance, Monsieur LeeuwenhOEK, qu'on vous ait accueilli au paradis des créateurs car vos travaux c'est de la roupie de sansonnet.
Pardonnez-moi, Monsieur Pasteur, mais mes découvertes n'étaient pas négligeables et quoique modeste drapier, j'ai fait faire un grand bon à l'humanité, j'ai
laissé une trace dans l'histoire, j'étais célèbre et un de mes amis, devenu un peintre renommé, Vermeer, m'a même pris comme modèle pour réaliser deux belles
toiles.
Baliverne que tout cela Monsieur Leeuwenhoek : votre microscope était une vulgaire loupe et vos microbes des animalcules qu'un bon myope voyait à l'œil nu.
Quant à votre Vermeer, ce marchand de tableaux endetté, j'aurais pu être un peintre bien plus renommé que lui car dès mes dix ans j'étais un remarquable
dessinateur et un peintre accompli ; seul mon dévouement à l'humanité souffrante m'a conduit à abandonner une riche carrière de peintre pour me livrer à la
science du vivant et faire progresser la médecine qui, avant moi, en avait bien besoin !
Alors qu'en est-il vraiment ?
Bien avant Leeuwenhoek les anciens comme Aristote (384-322 av JC), le père de la biologie, ou Hippocrate, celui de la médecine,
n'avaient pu observer de microbes car ils ne disposaient pas de l'outil qui permet cette observation, le microscope. Mais les anciens
suspectaient l'existence d'êtres invisibles, entités imperceptibles à l'origine de phénomènes au déterminisme obscur comme les
épidémies. Ils leur donnaient des noms : contagium vivum, germes disséminés, graines ou poissons malins, petits vers ailés.
Malheureusement il manquait ce fichu microscope pour vérifier l'existence de ces êtres invisibles à l'œil nu.
C'est donc bien à Delft et à Leeuwenhoek qu'on peut faire commencer l'histoire des microbes. Voilà une jolie vue de Delft(fig1) par
Vermeer*. Le tableau date de 1659-60, c'est une huile sur toile qui inspira Proust dans A la recherche du temps perdu
**. Il le considérait comme le plus beau tableau du monde.
* Vermeer a fait peu de toiles de paysages.
** Proust l'évoque dans le cinquième tome de la recherche (la prisonnière) au moment de la mort de Bergotte.
La découverte des microbes est en effet généralement attribuée au drapier Van Leeuwenhoek (1632-1723) (fig 2) contemporain de Vermeer. Ils sont nés la même année et ils se sont certainement bien connus puisque Leeuwenhoek a été l'exécuteur testamentaire de Vermeer et qu'on présume effectivement qu'il aurait posé comme modèle pour les tableaux le géographe et l'astronome (fig 3), une huile sur toile de 1668 (Musée du Louvre).



Fig 1 : vue de Delft, huile/toile. Fig 2 : Leewenhoek Fig 3 : l'astronome
Leeuwenhoek, esprit curieux, a examiné à l'aide de lentilles comme en utilisaient les drapiers toutes sortes d'objets microscopiques
mais, pour rétablir la vérité historique, il faut quand même indiquer que Leeuwenhoek a eu quelques rivaux dans l'utilisation du
microscope, ainsi Jan Swammerdam (1637-1680) que Michelet considérait comme le Galilée de l'infiniment petit. Fils d'un apothicaire
d'Amsterdam, il a pu découvrir à l'aide de cet instrument les organes des insectes et leur métamorphose Histoire générale des
insectes, (1669). Il a probablement observé les globules rouges du sang. Mais ses préoccupations scientifiques étaient étroitement
liées à des préoccupations religieuses : « je vous apporte dans l'anatomie du pou la preuve de la providence divine » dit-il.
Ainsi en cette époque de grande religiosité, la science ouvrait encore le chemin qui conduit à Dieu.
Le microscope de Leeuwenhoek, c'est vrai, Pasteur a raison, c'est une simple lentille mais soigneusement polie et fixée sur un support
permettant l'observation (fig 4). En dépit de sa rusticité ce dispositif permettait d'atteindre des grossissements allant jusqu'à 300
fois. Avec cet appareillage il fit de remarquables découvertes, observant la structure microscopique de graines, des petits invertébrés,
le bourgeonnement de l'hydre d'eau douce et les microorganismes de l'eau douce d'un lac situé à quelques lieues de Delft, les fameux
animalcules dont parle Pasteur. Il y observe de minuscules globules verts, des petits animaux avec deux pattes près de la tête et de
minuscules nageoires et il nous dit : « Le déplacement de la plupart était rapide et si élégant que j'avoue n'avoir jamais rien vu
de si admirable » . Il s'agissait de protozoaires et de microalgues que chacun peut observer à l'aide des petits microscopes
commercialisés. La fig 5 présente quelques-uns de ces petits microorganismes.


Fig 4 : une fameuse loupe Fig 5 : une goutte d'eau
Plus tard, on a donné des noms à tous ces petits êtres. Après que Linnée (1707-1778), le grand naturaliste suédois, ait proposé sa
monumentale classification des êtres vivants, Systema naturae, en 1735, l'année où Rameau présente les Indes Galantes, un zoologiste
allemand, Müller introduit, en 1776, des noms que gardera la classification moderne : Monas, Volvox, Paramecium, Vorticella,
pour désigner des petits microorganismes que l'on groupait sous le nom collectif d'infusoires. Erhenberg, naturaliste allemand, ami de
Humboldt, en donne une monumentale classification en 1838. Il serait à l'origine du mot bacterium si utilisé par la suite.
Finalement Ernst Haeckel (1834-1919) les classe (en1866) dans un troisième règne du vivant, celui des Protistes, organismes
unicellulaires, à côté des plantes et des animaux qui sont composés d'une multitude de cellules.
Leeuwenhoek a aussi découvert les globules rouges nucléés du sang de poissons et les spermatozoïdes. Mais surtout il révéla à l'homme le
monde bactérien : c'est ainsi qu'en 1683 observant la matière farineuse qui recouvre les dents il découvre les bactéries de la salive.
« Ces animalcules s'élancent dans la salive comme le brochet ou le brocheton dans la rivière, leur turbulence étant une preuve de
leur animalité » nous dit-il.
Il présente les sujets de ses observations à des visiteurs. A ce propos il écrit : « J'ai eu plusieurs dames dans ma maison qui
ont poussé des cris perçants en voyant les petites anguilles* du vinaigre : certaines étaient si dégouttées du spectacle qu'elles firent
vœux de ne plus jamais en employer. Mais qu'adviendrait-il si on révélait à de tels gens qu'il y a plus d'animaux vivant sur l'écume des
dents, dans une bouche d'homme, que d'habitants dans un royaume ».
* Les anguillules sont de petits vers parasites de la mère du vinaigre. L'alcool est oxydé en acide acétique, mais pour certains, à l'époque, l'acidité du vinaigre était due à l'irritation des papilles de la langue provoquée par les extrémités pointues des vers.
La notoriété de Leeuwenhoek était telle qu'il reçut de nombreux visiteurs de marque comme Pierre le Grand, Frédéric 1er de Prusse ou la reine Marie* d'Angleterre. Voici une image (fig 6) qui relate cette visite : la Reine examine un minuscule objet à l'aide d'un microscope sous le regard de Leeuwenhoek qui en tient deux autres exemplaires. Finalement on peut considérer que le drapier de Delft est un des fondateurs de l'histologie (étude des tissus) avec Malpighi et un des grands scientifiques de son époque.
*Il s'agit de Marie II Stuart, reine d'Angleterre, d'Irlande et d'Ecosse (1662-1694), Reine de 1689 à 1694 ; Ne pas confondre avec Marie Ière Tudor (Bloody Marie (1516-1558), mariée à Philippe II d'Espagne et Marie Ière Stuart (1542-1587), Reine d'Ecosse, mariée à François II de France, qui de retour en Ecosse lutte contre la réforme et Elisabeth Ière qui la fera décapitée.


Fig 6 : la visite Fig 7 : les premiers microscopes
Le "microscope" à une seule lentille était fatiguant à utiliser et le polissage des lentilles difficile, de plus tous les naturalistes
de l'époque n'avaient pas le savoir-faire de Leeuwenhoek pour construire ses petits "microscopes". Aussi les successeurs de Leeuwenhoek
utilisèrent-ils un microscope composé de plusieurs lentilles. Cet appareil a été inventé, semble-t-il, vers 1580 par deux opticiens
hollandais, Hans et Zacharias Janssen mais leur découverte fut longtemps oubliée, ainsi Descartes n'en fait pas mention dans sa
Dioptrique. Ce n'est que vers 1650 que le microscope composé fait son apparition mais les appareils (fig 7) fabriqués au XVIIème et
XVIIIème siècles souffraient de graves imperfections, on dit maintenant qu'ils présentaient des aberrations optiques.
Néanmoins Robert Hoocke (1635-1703), (fig 8), utilise ce type de microscope pour faire de belles observations qui sont résumées dans des
gravures sur cuivre de son Micrographia (1665).
Natif de l'ile de Wight, Hoocke est un scientifique éclectique, comme beaucoup à cette époque, cultivant la mécanique (loi de Hooke sur
l'élasticité), l'astronomie (télescope) ou l'horlogerie (échappement à ancre). C'est à lui que l'on doit le nom de cellule : il appelait
ainsi les alvéoles observées dans le liège qui sont limitées par le cadre rigide qui entoure les cellules vivantes chez les végétaux,


Fig 8 : Hoocke Fig 9 : coupe transversale dans une tige.
Mais dans le liège il s'agit de cadres vides de toute matière vivante. Cette belle coupe dans une tige (fig 9) montre les alvéoles
qu'observait Hoocke dans le liège. Leurs formes sont différentes selon le tissu auquel elles appartiennent. Il faut bien remarquer
que ni Hoocke, ni Malpighi qui fit des observations analogues, ne sont à l'origine du concept de cellule qui ne se précisa que deux
siècles plus tard avec Schleiden et Schwann qui élaborent la théorie cellulaire : tout organisme vivant est composé de cellules.
Dans la conversation, Leeuwenhoek cherche à montrer la valeur de ses travaux.
Et je dois vous dire, Monsieur Pasteur, que j'ai envoyé de nombreuses publications relatant mes observations à la Royal Academy qui m'a
même fait membre associé.
Mon cher Leeuwenhoek, vos soi-disant découvertes ne sont restées dans l'histoire que parce que vous vous êtes fait de la publicité en
envoyant quelques notules à la Royal Academy et en recevant quelques royales personnalités que la vue de petites bêtes dans une goutte
d'eau de gouttière pouvait amuser. Et vos soi-disant publications n'étaient même pas écrites en latin ou en anglais, des langues que
vous ignoriez. Mais vous avez eu bien de la chance qu'un vrai savant, de Graaf, accepte de les présenter à l'Academy. Et d'ailleurs vos
soi-disant travaux marquent si peu l'histoire que les autres microscopistes de votre époque oublient d'en parler. D'ailleurs ces
microscopistes-là sont bien comme vous : ils ne relatent que des observations saugrenues.
Qu'en est-il vraiment ?
Pasteur a tort : Leeuwenhoek ne transmis pas quelques "notules" mais plus de 300 lettres à la Royal Academy*, toutes rédigées en
hollandais. Certaines furent présentées par Régnier de Graaf, un brillant anatomiste. Ces lettres, largement traduites, furent publiées
dans les Philosophical transactions qui était la revue de la Société Royale. En 1680 Leeuwenhoek avait été nommé membre associé à la
Société Royale de Londres.
*La Royal Society est créée en 1660 et les Philosophical transactions en 1665. L'apologétique scientifique a trouvé son expression
parfaite avec Robert Boyle et les autres savants anglais de cette société : pour ces hommes croyants l'étude de la nature avait pour
but principal la glorification de Dieu et de ses œuvres.
Mais Pasteur a raison quand il critique les premières publications des microscopistes. Certains font preuve d'une inquiétante imagination : par exemple Louis Joblot (1645-1723), par ailleurs professeur de mathématiques, publie en 1718 les résultats d'une trentaine d'années d'étude faites avec plusieurs types de microscopes. Voici une reproduction d'une des planches, plutôt fantaisistes, qui illustrent ses observations (fig 10). Il fait aussi preuve d'imagination dans la dénomination des microbes qu'il observe, les nommant poissons, chenilles, pantoufles ou cornemuses. Sa représentation des spermatozoïdes est pour le moins originale : ils portent une barbiche ; d'autres auteurs n'étaient pas plus exacts dans leurs observations les dotant d'un anus et d'un orifice génital.

Fig 10 : illustrations de Joblot
Mais la pensée scientifique du moment n'a que faire de ce petit monde grouillant dans des gouttes d'eau de gouttière : ces animalcules ne présentent pour beaucoup qu'un sujet d'émerveillement devant la générosité de la nature ou qu'un sujet de distraction pour amateur de science amusante. En revanche, certains comme Buffon*, voient dans ce grouillement une « véritable insulte aux êtres vivants » et en particulier au premier d'entre eux : l'homme. Georges louis Leclerc, comte de Buffon, n'en reste pas moins un des grands naturalistes français, intendant du jardin du Roi dont il fait un des premiers jardins botaniques d'Europe et auteur d'une gigantesque Histoire naturelle en 36 volumes.
*Georges-Louis Leclerc (1707-1798), comte de Buffon. Né à Montbart, collège des Jésuites à Dijon, académie des Sciences (1734) comme adjoint- mécanicien, puis adjoint-botaniste (1739). Intendant du jardin du Roi dont il fait le premier Jardin botanique d'Europe. Son Histoire naturelle en 36 volumes traite de toutes les sciences naturelles et même de l'origine du système solaire. Baptisé « grand phrasier « par d'Alembert suite à son discours sur le style pour son intronisation à l'Académie française et de sa propension aux spéculations philosophiques aux détriments de l'information scientifique.
Vous avez peut-être raison, Monsieur Pasteur, les publications des premiers microscopistes manquaient parfois de sérieux et ils n'ont
pas su faire rentrer leurs observations dans le domaine de la science ni convaincre des savants de l'époque comme Buffon, mais il est
un domaine où ces premiers travaux, et tout particulièrement les miens, apportaient beaucoup à la connaissance ce fut celui de la
génération, un domaine que vous n'avez jamais étudié que je sache, peut-être parce que, catholique respectueux des dogmes religieux
et de la morale du second empire, vous vous êtes bien gardé d'aborder la sulfureuse question des sexes et de la reproduction.
Leeuwenhoek a raison, s'il y avait un domaine prêt à accueillir les révélations du microscope c'était bien celui de la génération par
les parents, le rôle des sexes et la formation du fœetus.
La question était ancienne : un disciple de Pythagore, Alcmeon de Crotone, prétendait que la semence était une manifestation visible du
cerveau ; pour Parménide, elle trouvait son origine dans le sang. Pour Démocrite, le tenant de l'atomisme, la semence provenait de
toutes les parties du corps, c'était la théorie pangénétique qui imprégna la médecine Hippocratique. Pour Empédocle, la figure la plus
bariolée de la philosophie grecque selon Nietszche, le fœtus était bien le résultat du mélange des semences, mais ses parties nobles
dérivaient (bien entendu) du sperme paternel. Aristote et Hippocrate, admettaient eux-aussi que le fœtus provenait du mélange des
semences mais que la part des deux sexes était inégale : « le mâle fournit la forme et le principe du mouvement, la femelle le corps
et la matière » disaient-ils.
Dans ses nombreux écrits, souvent transmis par des traductions arabes, Galien, le dernier grand médecin romain, indique, lui aussi,
qu'il existe une semence mâle et une femelle et que la formation du fœtus est analogue à celle de l'embryon d'une plante. Mais les
œuvres encyclopédiques de Galien ou de Pline se révélèrent incapables de susciter de nouvelles connaissances, aussi le seul aspect de
la génération que pouvait aborder l'âge classique, faute de moyens, c'était ce que contient la semence de chaque sexe.


Fig 11 : Les philosophes présocratiques Fig 12 : Galien (129-201)
Par un heureux hasard, au début de la Renaissance, on manifeste un regain d'intérêt pour l'anatomie. Avec Vésale* (1514-1564), le grand anatomiste qui disséquait les corps des pendus du gibet de Montfaucon, l'étude des cadavres s'est généralisée. A force de fouiller les corps on a pu observer dans les "testicules" des femelles de mammifères vivipares des globules (que l'on nomme maintenant follicules de De Graaf) et même établir qu'il y a corrélation entre leur nombre et celui des embryons dans la matrice. Ces globules seraient des œufs contenant un petit fœtus déjà formé (théorie de la préformation). Ainsi, à la fin du XVIIème siècle, on admet que les femelles ont des œufs, ce qui fait glousser d'horreur les précieuses déjà ridicules depuis Molière (1659) : elles protestent d'être prises pour des poules.
*André Vésale, né à Bruxelles, est le grand anatomiste de la Renaissance. Il appartient à une famille de médecins, un ancêtre était médecin de Charles le Téméraire, son grand-père médecin de Maximilien 1er, empereur du Saint-Empire et son père apothicaire de Marguerite d'Autriche, un temps fiancée à Charles VIII de France qui la délaisse pour Anne de Bretagne. Il commence ses études de médecine à Louvain puis en 1533 s'installe à Paris, rue de la Grange-aux- Belles, tandis que nait son intérêt pour l'anatomie. Il s'entraine alors à disséquer les corps des pendus du gibet de Montfaucon tout proche. En 1543 il publie ses observations dans le De humani corporis fabrica libri septem, la structure du corps humain, dont des illustrations seraient dues à des peintres de l'école du Titien.
Avec la découverte des spermatozoïdes Leeuwenhoek affirme (1679) « qu'il n'y a pas autant d'hommes à la surface du globe que d'animalcules dans la laitance d'un seul mâle » , tout en spécifiant bien que cette observation n'a pas été faite aux dépends de sa propre postérité. Mais ces animalcules que le microscope révèle dans la semence des mâles on ne sait trop qu'en faire tant il paraît que le germe du petit être réside dans l'œuf. Pour des naturalistes de l'époque la semence mâle n'avait qu'un rôle mineur, une partie seulement de celle-ci, la plus subtile, la vapeur séminale, l'aura seminalis, avait pour rôle de réveiller le fœtus déjà préformé dans l'œuf. Cette idée avait inspiré des théologiens : pour expliquer l'immaculée conception, ils proposaient que le souffle de l'esprit saint remontant dans les trompes mariales avait suffi pour animer "l'œuf Jésus" que Marie portait en son sein (Pierquin, 1742). Spallanzani, plus réaliste, mettait de petits caleçons aux mâles des grenouilles* pour montrer que les pontes des femelles ne peuvent donner des tétards que si elles sont arrosées par la laitance des mâles.
*Réaumur avait eu la même idée mais les petits caleçons étaient probablement mal ajustés et les mâles réussissaient à s'en débarrasser : les pontes, arrosées par "la fumée de pipe" donnaient des tétards.


Fig 13 : dessins de Vésale, de Graaf et Hartsoecker
Mais certains font l'hypothèse inverse : ce ne sont pas les œufs qui portent en eux le germe mais bien les animalcules qui s'agitent
dans la semence mâle. Leeuwenhoek et Nicolaas Hartsoecker (1656-1725) sont de ceux-là. Hartsoecker figure en 1694 un spermatozoïde avec
un petit homme, genoux repliés sous le menton, en position fœtale. Pour eux le rôle de la femelle se cantonne à héberger le petit germe
et à le nourrir.
Il est vrai, Monsieur Leeuwenhoek, que je ne me suis pas intéressé à la reproduction des animaux et des plantes mais le monde de
l'infiniment petit et mes travaux destinés à soulager les souffrances de l'humanité ont suffi à occuper toute ma vie. Mais je crois
quand même savoir que ce n'est pas vous qui avez le premier vu les spermatozoïdes mais un jeune étudiant en médecine, Louis de Ham, qui
les avaient observés dans la semence d'un homme atteint de chaude-pisse et qui vous en avait averti, mais passons. Et vous qui parlez de
génération, je vous rappellerai quand même que j'ai réfuté de manière exemplaire et définitive la génération spontanée, une doctrine
inepte que défendaient vos contemporains et un botaniste rouennais du nom de Pouchet.
En fait, Monsieur Pasteur, je crois savoir que la démonstration fut surtout péremptoire car vous étiez bien introduit auprès des membres
de l'Académie des Sciences dont vous faisiez partie et qu'ils ont tranché en votre faveur sans même entendre le pauvre Pouchet. Vous
avez même considéré comme nuls les résultats de certaines expériences de Pouchet sans les avoir refaites pour vérifier ses dires.
Dans cette histoire de génération spontanée Leeuwenhoek a en partie raison, en partie tort. Voyons ce qu'il en est.
La génération spontanée c'est la formation d'êtres vivants à partir de la matière inanimée. L'idée est due à Aristote (384-322 av JC).
De longue date cette idée avait été l'objet de discussions vives. Depuis Van Helmont (1579-1644) qui voyait apparaître spontanément des
souris dans un vase de froment ou des scorpions dans une brique creuse contenant du basilic ou depuis Buffon qui, emboitant le pas à
Démocrite (460-370), ne voyait pas d'objection à l'édification d'êtres vivants à partir de l'agrégation de molécules organiques, la
génération spontanée avait de nombreux adeptes. Pourtant les contestataires, Rédi (1668) ou Spallanzani (1769), avaient apporté des
preuves expérimentales montrant que la génération spontanée était bien peu vraisemblable. A l'époque de Pasteur on admettait leur
conclusion pour les organismes supérieurs mais certains prétendaient encore que la génération spontanée pouvait intervenir chez les
animalcules que révélait le microscope. Pouchet (fig 14) était de ceux-là.
Pasteur est entraîné dans la querelle sur la génération spontanée à la suite d'une communication de Pouchet et de la publication en
1859 de son livre Hétérogénie, traité de la génération spontanée. Pouchet, médecin et naturaliste rouennais, était un véritable
scientifique reconnu par l'Académie. Devant l'importance de cette question soulevée par Pouchet, l'Académie proposa un prix pour qui
répondrait à la question « Essayer par des expériences bien faites de jeter un jour nouveau sur la question des générations spontanées
». Pasteur était opposé à la génération spontanée d'abord par conviction résultant de ses travaux sur les fermentations mais aussi par
convictions religieuses et philosophiques. Ces dernières étaient d'ailleurs en parfait accord avec les positions de l'église et celles
de l'Empereur Napoléon III ; elles lui permettaient d'avoir une position enviable dans l'entourage de la cour impériale.

Fig 14 : un mot sur Pouchet
Pasteur relève donc le défi et procède à une étude historique approfondie. Mais on ne peut ignorer qu'une partie des conceptions de Pasteur sur la génération spontanée trouvait son origine dans les travaux de Schwann et les enseignements de Claude Bernard à la Sorbonne que Pasteur, pourtant déjà connu par ses travaux dans le monde scientifique, avait suivi comme un simple étudiant.


Fig 15 : ballons à col de cygne et Pasteur présentant le résultat d'une expérience.
Il est certain aussi que l'idée d'utiliser les fameux ballons à col de cygne (fig 15) pour réfuter la génération spontanée avait été
suggérée à Pasteur par son maître de thèse, le chimiste Balard. Mais on doit aussi remarquer l'extrême diversité des dispositifs et des
expériences que Pasteur invente pour répondre à toutes les objections. Néanmoins, plus que dans ses autres travaux, l'originalité de
Pasteur est ici relativement faible car il ne fait que reprendre la vieille théorie de la dissémination des germes par l'air. Mais il
compense son manque d'originalité par la diversité des démonstrations, emportant même à diverses altitudes, dans le Jura et jusqu'au
glacier du Montenvers, des ballons scellés contenant un milieu nutritif stérilisé, ballons qu'il ouvrait pour faire pénétrer l'air pur
de la montagne avant de les sceller à nouveau. Dans la plupart des flacons ouverts à cette altitude aucun microorganisme ne se
développait. Mais Pouchet conduisit des expériences du même type sur l'Etna puis les Pyrénées et lui trouva souvent des contaminations.
Malgré les incertitudes sur les résultats obtenus par ces deux auteurs dans cette histoire de flacons contaminés ou non, une commission
de l'Académie fut nommée dont les membres étaient acquis à Pasteur. Elle n'entendit que Pasteur et en 1865, elle entérine tous les
résultats de Pasteur. Ainsi se clôt la controverse avec Pouchet. Pourtant la démonstration était moins rigoureuse qu'il y paraissait :
Pasteur n'avait même pas refait les expériences de Pouchet, En particulier les milieux de culture contenus dans les flacons étaient
différents : infusion de foin chez Pouchet et eau de levure sucrée chez Pasteur. Or plus tard, vers 1875, on a montré que le foin peut
contenir des bacilles aérobies sporulés. Les spores auraient pu résister à la stérilisation des flacons et germer ensuite lorsqu'on les
ouvrait. Finalement la "génération spontanée" observée par Pouchet n'était vraisemblablement qu'un phénomène de reviviscence induit par
l'oxygène. Les affirmations de Pasteur étaient donc justifiées. Pour clore ce débat avec beaucoup de mauvaise foi, on pourrait dire,
parodiant Shakespeare, beaucoup de bruit pour rien.
Monsieur Pasteur je ne vais pas contester vos résultats concernant la génération spontanée à laquelle je n'ai moi-même jamais cru, mais
je croyais à la préformation des germes, une théorie à la mode à mon époque. Mais je me trompais. Moi je reconnais mes erreurs.En
revanche vous n'avez pas toujours reconnu les vôtres. Par exemple, Monsieur Pasteur, à la suite de vos brillants travaux de chimiste
vous avez étudié les fermentations, avec succès je dois dire, mais sur ce point vous étiez en désaccord avec des auteurs allemands
Buchner et Hahn et l'illustre chimiste Berthelot, un homme modeste qui bien que brillant élève avait refusé, comme son ami Renan, de
faire une grande école. Vous prétendiez en effet que les fermentations étaient essentiellement l'œuvres de microbes vivants, en cela
vous étiez vitaliste, alors qu'eux les attribuaient à des sortes de ferments purement chimiques. Et c'est eux qui avaient raison et vos
colères n'y changèrent rien.

Fig 16 : controverse entre Pasteur et Berthelot
Il est vrai que Pasteur considérait que seules les levures vivantes pouvaient fermenter car il avait observé que les cellules mortes
perdaient cette faculté. Il prétendait aussi que les levures ne pouvaient fermenter qu'en absence d'oxygène. Or, deux allemands, Buchner
et Hahn contestaient ce point de vue. Ils avaient constaté que les levures fermentent en présence d'oxygène à la condition qu'il y ait
beaucoup de sucre dans le liquide de fermentation.
Or, en 1878, après la mort de Claude Bernard, Marcelin Berthelot fit état dans la Revue scientifique d'une série d'expériences de
Bernard destinées à réfuter la théorie pastorienne des ferments vivants. Lorsque Pasteur prit connaissance de l'article, il entra,
dit-on, dans une grande colère et se mit à arpenter son laboratoire de long en large, traitant cette publication d'infamie et traitant
Berthelot d'infâme et de malhonnête, capable de tout et concluant : « cet homme est capable de tout, de tout vous dis-je, cet
homme il doit tromper sa femme !!! » . Il fit paraître une réponse sous le titre :réponse à un écrit posthume de Claude Bernard.
Marcelin Berthelot, magnanime, n'en sera pas moins l'auteur d'une analyse élogieuse des travaux de Pasteur parue dans le Figaro à la
suite du décès du grand homme en 1895.
Un peu avant, en 1893, Buchner et Hahn, à l'université de Kiel, donnaient raison à Claude Bernard et à Berthelot. En effet, ils avaient
pu moudre de la levure avec un mélange de sable et de terre d'infusoires, obtenir un extrait liquide que, pour éviter qu'il ne s'infecte
rapidement, ils avaient additionné de sucre de canne. A leur étonnement, ils observèrent une forte effervescence et la fabrication de
gaz carbonique et d'alcool, comme avec des levures vivantes, ce qu'ils attribuèrent à un principe actif qu'ils appelèrent zymase. Cette
zymase se révéla par la suite constituée de plusieurs composés que l'on nomma collectivement "enzymes glycolytiques". Pour sa découverte
de la fermentation acellulaire, Buchner obtint le prix Nobel en 1907. Ce résultat important sonnait le glas du principe vital pastorien
et ouvrait la voie à la biochimie moderne.
Bon, Je me suis trompé, je vous l'accorde. Mais si je n'avais pas montré que les molécules de la vie sont dissymétriques la biochimie,
cette chimie du vivant, ne serait jamais née. Et leur zymase, elle est fabriquée par qui, Monsieur le drapier,..par des cellules
vivantes. J'y tiens, Monsieur le drapier : une cellule vivante donne une cellule vivante : je suis vitaliste et non comme ces
biochimistes prétentieux pour qui la vie nait dans une soupe primitive bombardée de rayons ultraviolets. Je suis vitaliste et je le
reste.
C'est vrai, Monsieur Pasteur, et cela n'a pas nui à votre notoriété en France qui tenait surtout à l'image de grand savant désintéressé
découvrant l'origine des maladies et sauvant des vies par la vaccination. Mais, si je ne me trompe pas, vous n'avez découvert aucun des
microbes qui provoquaient les grandes pandémies. Je pense à la peste, je pense à l'agent du choléra qui vous échappe aussi bien lors de
l'épidémie de 1853-54 qui fit de grands ravages en France que pendant l'expédition que vous envoyez en Egypte pour étudier la cinquième
pandémie de 1880 et qui malheureusement se solde par le décès de votre collaborateur Thuillier. Je pense aussi au microbe de la tuberculose,
isolé par votre rival Robert Koch que vous traitiez de "petit médecin de province".
Pasteur devient tout rouge de colère :
Monsieur le petit drapier de Delft révisez vos connaissances et vous saurez que ce sont mes
premiers travaux sur la culture des microbes des fermentations qui ont permis ces découvertes et que j'ai été un précurseur dans l'étude
du charbon et de la gangrène gazeuse et que j'ai découvert les staphylocoques du furoncle, et que j'ai inventé l'asepsie et que j'ai
mis au point les vaccinations et que j'ai créé un institut et une école de pensée qui a essaimée dans le monde .....
Essayons de voir plus clair dans cet échange musclé.
Après leur découverte tous les êtres microscopiques n'ont pas tout de suite trouvé leur emploi. Certes, certains auteurs pensaient
qu'ils jouaient un rôle dans la transmission des maladies. Déjà Rabelais dans son Pantagruel ou son Gargantua (1534) suspectait qu'un
petit animalcule (maintenant baptisé sarcopte) était à l'origine de la gale, ce que démontrent plus tard Bonomo et Cestoni (1687). Mais
il faut attendre le début du XIXème siècle pour qu'on montre avec le microscope que des microorganismes peuvent être à l'origine de
maladies : on retiendra les noms de Henle, Cagniard de Latour ou Agostino Bassi. Ce dernier montra qu'une maladie du ver à soie était
due à un champignon et qu'elle était contagieuse (1835). Il attribua plus tard la
rougeole, la syphilis ou la peste à des parasites vivants.


Fig 17 : sang et bacille du charbon Fig 18 : bacille de la fermentation butyrique
Mais la démonstration est faite quand Davaine et Rayer (1850) montrent que le charbon du mouton est transmissible par inoculation et que Pacini découvre en 1864 le bacille du choléra, dans l'indifférence générale. Dans le sang charbonneux Casimir Davaine observe des petits corps filiformes (fig 17) dont la longueur est le double de celle d'un globule sanguin. Pourtant il n'interprète vraiment ses observations que dix ans plus tard après avoir pris connaissance du travail de Pasteur sur la fermentation butyrique (1861) qui montrait qu'elle était provoquée par un bâtonnet (fig18)* analogue à celui du charbon. Ainsi l'importation de l'idée du déterminisme de la maladie par un agent vivant est-elle due au médecin, Davaine, et non au chimiste, Pasteur, mais ce dernier la conforte par ses observations sur le rôle des microbes.
*On voit la bactérie responsable de la fermentation butyrique : il s'agit d'un bâtonnet qui donne naissance à une forme de résistance : la spore. Pasteur avait montré que ces bactéries tirent leur énergie de la fermentation des sucres en l'absence d'air, on dit en anaérobiose. Il se forme de l'acide butyrique et du gaz carbonique.
Finalement, au milieu de XIXème siècle, on s'accorde pour trouver une fonction aux plus petits des êtres décelés par le microscope,
les bactéries : agent de fermentations (travaux de Pasteur sur le vinaigre et le vin) ou agent causal de maladies chez l'animal
et l'homme comme le montrent déjà les travaux de Davaine ou ceux de Pacini.
Si les années 1860-1870 préparent les principales découvertes sur les microorganismes pathogènes, c'est aussi l'époque des
ravissantes scènes de plage (fig 19) que peint Eugène Boudin. Probablement sous l'influence de Jongkind, le dessin de Boudin
devient plus impulsif et sa couleur plus vive.


Fig 19 : Eugène Boudin, scènes de plage
Ses toiles offrent de précieux documents sur les habitudes estivales de l'époque. Sur le sable de Trouville ou de Deauville tout un
petit monde de cette fin d'Empire papote, en huiles ou en aquarelles, bien loin des petits monstres qui peuplent les bouillons de
culture de nos chercheurs de microbes. La fin du XIXème siècle sera la belle époque de la bactériologie, la fonction des microbes est
enfin comprise. L'un des acteurs majeurs en bactériologie est Robert Koch.
Heinrich Hermann Robert Koch (1843-1910) est un médecin allemand, fils d'un ingénieur minier, qui fit ses études à Göttingen avec
d'éminents professeurs comme Jacob Henlé ou Friedrich Wöhler (synthèse de l'urée). D'abord médecin de ville, il fit ses premières
découvertes alors qu'il était médecin cantonal près de Poznan en Silésie. Il redécouvre le bacille du charbon et celui du choléra déjà
observé par Pacini mais surtout il isole l'agent de la tuberculose (1882). A partir du bacille tuberculeux il avait extrait une
substance qu'il avait baptisée tuberculine et avec laquelle il prétendait guérir la tuberculose. Malheureusement le produit provoqua des
décès et fut abandonné. La tuberculine utilisée actuellement pour mettre en évidence la positivité au BK, c'est-à-dire que le
sujet non malade a été en contact avec la bactérie, est d'une autre nature. Vers la fin de sa carrière (à partir de 1896) il s'intéressa
aux maladies tropicales.
Sur la figure 20 on voit Robert Koch dans son laboratoire, entouré de toute une verrerie, boites de Pétri pour la culture des bactéries
et cuves à coloration. Koch a en effet mis au point des méthodes de culture pour les microorganismes et des techniques de coloration
pour les mettre en évidence. La figure 21 présente le bacille tuberculeux dans du tissu pulmonaire. Le bacille est assez filamenteux et
plutôt difficile à mettre en évidence Il faut utiliser une coloration spéciale (méthode de Ziehl-Neelsen). L'hôte réagit à l'infection
en formant des tubercules autour des foyers où se développe la bactérie. En 1884, Koch publie un gros traité sur l'étiologie de la
tuberculose.

Fig 20 : Robert Koch Fig 21 : bacille tuberculeux
Par ses travaux éminents Koch accède au poste de Professeur d'hygiène à l'Université de Berlin (1885) puis obtient le prix Nobel en 1905.
Son nom reste associé aux règles permettant de vérifier qu'un agent pathogène est bien responsable de la maladie qu'on lui attribue
(postulats de Koch, règles déjà énoncées par Henlé). Adepte de la microphotographie, il obtient les premiers clichés de bactéries. Mais
il faut rappeler qu'il a été précédé dans le domaine de la culture des bactéries sur des milieux nutritifs par l'abbé Lazzaro
Spallanzani (1729-1799) qui faisait croître des microorganismes sur des jus de viande. La culture des microorganismes n'est pas
évidente, : pour le moment on ne sait pas cultiver in vitro le tréponème ou le bacille de la lèpre. C'était aussi le cas de
l'agent de la maladie de Whipple (Tropheryma whipplei) , une infection intestinale chronique (1907) jusqu'à ce que Didier Raoult le
cultive (en 2000).
A partir de 1880, en une vingtaine d'années, on découvre des agents responsables des grandes épidémies : Eberth isole l'agent de la
fièvre typhoïde (Salmonella typhi,1880) , Koch celui du choléra (Vibrio cholerae, après Pacini) et celui de la
tuberculose (Mycobacterium tuberculosis,1882). Nicolaïer puis Kitasato isolent l'agent du tétanos (Clostridium tetani,
1884, 1889) ), Klebs et Loeffler celui de la diphtérie (Corynebacterium diphteriae,1884) , Yersin celui de la peste
(Yersinia pestis,1894) et Shiga l'agent de la dysenterie bacillaire (Shigella,1898). Le bacille tétanique, comme celui
de la fermentation butyrique, ne peut vivre qu'en absence d'air. Il prolifère dans les plaies profondes. Il libère une toxine* qui
diffuse dans le sang et atteint les tissus nerveux. Elle provoque, dans les stades avancés de la maladie, des contractures et des
convulsions toniques des muscles striés, le trismus et l'opisthotonos (fig 22)

Fig 22 : Opistotonos
*La toxine est libérée dans la plaie par la lyse des bactéries. Cette neurotoxine (tétanospasmine) bloque les synapses inhibitrices des neurones moteurs de la moelle et empêche la libération du gamma-aminobutyrique et de la glycine, ce qui provoque une stimulation incontrôlée des muscles striés. Raideur de la mâchoire, trismus (sourire sardonique), spasmes et contractures des muscles du tronc se succèdent. La prévention du tétanos associe l'anatoxine et des sels d'aluminium. Cette anatoxine est associée à l'anatoxine diphtérique et au vaccin anti-coquelucheux (Bordetella pertussis et parapertussis) dans le DTCoq. La maladie, difficile à traiter, est assez commune chez les toxicomanes.
En France, Emile Roux (1853-1953) isole avec Pasteur, le staphylocoque des furoncles (fig23) et l'agent de la fièvre puerpérale.


Fig 23 : furoncle et staphylocoques Fig 24 : Emile Roux Fig 25 : Alexandre Yersin
En 1878, sur recommandation de Duclaux, Roux (fig 24) devient le collaborateur de Pasteur qui cherchait un assistant ayant des connaissances médicales pour poursuivre ses travaux sur l'origine des maladies microbiennes. En 1887, Roux devient directeur du laboratoire de la rue d'Ulm. C'est là qu'avec Yersin (fig 25), qu'il a pris comme collaborateur, il met au point le sérum antidiphtérique, jetant les bases de la sérothérapie*. En 1904 Roux est nommé Directeur de l'Institut Pasteur, il le restera jusqu'à sa mort en 1933.
*La grande découverte de Roux c'est la sérothérapie qu'il partage avec Von Behring et Kitasato, technique qui permet de transférer passivement l'immunité. L'intérêt de Roux pour la diphtérie est du, pour une part, à l'emplacement de l'Institut Pasteur à proximité de l'hôpital des enfants malades. Avec Yersin en 1888, il isole le "poison diphtérique" à partir de cultures de Corynebacterium, on n'utilisait pas alors le terme de toxine. En 1891, Roux commença à étudier l'immunisation sur de grands animaux, en particulier des chevaux et, à partir de 1894, il mena une série de recherches sur la production de sérum avec Louis Martin et des médecins de l'hôpital des enfants malades. Plus de trois cents cas furent traités avec le sérum. Néanmoins la technique d'immunisation fût critiquée mais cela n'empêcha pas l'ouverture d'une campagne de souscription pour « le vaccin du croup » lancé par le Figaro puis, plus tard, l'obtention d'une subvention de l'Etat.
Quant à Alexandre Yersin (1863-1943) c'est un médecin d'origine suisse. Il fait ses études à Lausanne, à Marbourg puis à Paris à
l'Hôtel-Dieu où il rencontre Roux. Naturalisé français en 1887, il devient préparateur du cours de microbiologie de l'Institut, le
cours de microbie technique (1889). A partir de 1890, il entame une vie de recherche et d'aventure dans les régions montagneuses de
l'Annam. En 1894, il s'installe à Hong Kong menacé par une épidémie de peste provenant de Mongolie. C'est là qu'il isole l'agent de la
peste, en compétition avec une équipe japonaise venue tout exprès à Hong Kong pour étudier la maladie. En 1895, il crée l'Institut
Pasteur de Nha Trang en Annam.
Comme lui de nombreux pastoriens ont créé des Instituts dans toutes les parties du monde : en Afrique (Alger, Tunis, Guinée, Madagascar)
, en Amérique (Guadeloupe, Guyane, Uruguay) en Asie (Cambodge, Laos, Nouvelle Calédonie), assurant le rayonnement de la science
française et perpétuant l'école pastorienne.
On doit aussi à Pasteur "l'invention" de l'asepsie en complément de l'antisepsie que défendait le chirurgien anglais Lister. Lister
avait fait ses études de médecine à Londres (1852) puis il est nommé professeur de chirurgie à Glagow. Dans son service hospitalier il
observe les ravages de la gangrène lors des amputations. Adepte de la théorie des germes prônée par Pasteur, il propose de les détruire
dans les plaies à l'aide de l'acide phénique. Pasteur, lui, propose l'asepsie, c'est à dire non pas détruire les microorganismes dans
les plaies mais les empêcher de les contaminer « Si j'avais l'honneur d'être chirurgien, dit Pasteur devant l'Académie de
médecine en 1878, je n'emploierais que de la charpie, des bandelettes et des éponges préalablement exposées à un air porté à la
température de 130 à 150 °C et je n'emploierais jamais qu'une eau qui aurait subi la température de 110 à 120 °C » . En ce sens
Pasteur est un successeur de Semmelweis*
*Semmelweis (1818-1865), médecin à l'hôpital général de Vienne, observe que la mortalité des femmes enceintes par fièvre puerpérale est très différente dans 2 salles de l'hôpital (30% et 3%). En examinant le corps d'un médecin décédé d'une coupure à la suite d'une autopsie , il constate que les tissus malades sont analogues à ceux des femmes décédées dans la salle à forte mortalité. Or cette salle était visitée par les étudiants et médecins qui sortaient de la salle où se pratiquaient les autopsies. Il conseille un lavage soigneux des mains au phénol en sortant d'une autopsie : la mortalité chute. Semmelweis meurt en 1865 dans un hospice, à la suite d'une septicémie due à une petite intervention.
Eh Oui, Monsieur Pasteur, vous avez inventé l'asepsie et prôné la vaccination, mais même dans ces domaines vous n'êtes pas le premier,
plusieurs vous précèdent, Semmelweiss pour l'asepsie et pour les vaccinations les orientaux, Jenner et, à la fin du XIXème siècle, votre
époque, les vétérinaires qui vaccinaient contre le charbon ou la rage. Et même les tentatives du peu connu médecin Auzias-Turenne,
vaccinant contre la syphilis, précèdent vos travaux..
La deuxième moitié du XIXème siècle, est en effet la belle époque des vaccinations.
Mais de telles mesures préventives étaient connues depuis fort longtemps en Inde puis en Chine dans le cas de la variole : on
introduisait des excoriations de pustules de varioleux dans le nez. La variolisation s'était répandue en Turquie au XVIème,
puis en Europe au XVIIème où elle fut introduite par Lady Wortley Montagu, femme de l'ambassadeur anglais en Turquie. Selon Voltaire,
dans son dictionnaire philosophique, la variolisation se pratiquait aussi en Arabie où les femmes Géogiennes et Circassiennes, fort
appréciées dans les harems des sultans Ottomans, étaient inoculées avant d'être vendues. La pratique était finalement fort répandue.
Aussi lorsque Louis XV mourut en quelques jours de la variole, en 1774, à 64 ans, cette mort tragique eut pour conséquence de
convaincre la cour de se faire varioliser. La variolisation* eu lieu à Marly : on inocula le Roi Louis XVI, le comte de Provence
(futur Louis XVIII) et le comte d'Artois (futur Charles X).
*On fit appel à un inoculateur à la mode, Jouberthon ainsi qu'au premier médecin des Camps et Armées de sa majesté, un certain Richard.
La variolisation n'était pas sans dangers, aussi un grand progrès est accompli lorsque Jenner (1749-1823) montre qu'une préparation de
vaccine, une forme bénigne de variole de la vache
(picote ou cow-pox) , protège l'homme de ce redoutable fléau. Pour rendre hommage à Jenner Pasteur nomme vaccination ce mode
immunisation.
On expérimentait aussi la vaccination contre d'autres maladies. Partant du principe que la syphilis présente des symptômes cutanés comme
la variole, un certain médecin Auzias-Turenne (1812-1870) expérimente la syphilisation sur le singe. En 1848, à l'hospice de
l'Antiquaille à Lyon, on inocule des patients avec le sang d'un malade atteint de syphilis tertiaire, la forme ultime de la maladie. On
pratique des inoculations successives et divers médecins français ou italiens développent des méthodes analogues. Certains pensent que
l'on devrait « syphiliser toutes les filles publiques, les militaires et les marins » , bref tous ceux susceptibles d'être
contaminés par l'agent de la syphilis. Celui-ci, le tréponème pâle (Treponema pallidum) *, ne sera découvert qu'en 1905 par
Schaudinn et Hoffmann.
*Une bactérie voisisne, Treponema endemicum, donne une sorte de syphilis endémique atteignant les os et la peau.
En 1851, une prostituée de 34 ans reçoit 57 inoculations. Son ventre est couvert de cicatrices et de quatre chancres suppurants qu'il
faudra cicatriser. Le Docteur Auzias-Turenne sollicite même l'autorisation de syphiliser toutes les prisonnières de l'hôpital-prison
Saint-Lazare mais cela lui est refusé (1853). Tous ces essais restent sans suite même si Roux et Metchnikoff reprennent des essais de
syphilisation sur le singe en 1879. On voit combien l'expérimentation vaccinale peut-être aléatoire et souvent risquée pour les patients.
La figure 26 présente un chancre syphilitique et le portrait du Dr Auzias-Turenne. Le chancre est une petite lésion localisée
généralement au voisinage des organes sexuels et qui grouille de tréponèmes. Quant au portrait, c'est celui d'un homme déterminé. Il
porte une décoration décernée par un ordre suédois. En dehors de la syphilisation, il prôna le traitement de certaines maladies par
antagonismes bactériens.


Fig 26 : chancre et portrait du docteur Auzias-Turenne Fig 27 : Ingres, le bain turc
Oubliant la syphilisation, avec Ingres (1780-1867), nous retrouvons les belles odalisques au bain turc, une œuvre de 1859 (fig 27). On
conçoit qu'il était utile de varioliser toutes ces belles anatomies afin de les protéger de l'horrible maladie qui, vérolant leur visage,
aurait gâchée la marchandise.
Pasteur et ses collaborateurs ont beaucoup œuvré dans le domaine des vaccinations : vaccin contre le choléra des poules, contre la
maladie du charbon, le rouget du porc et bien sûr la rage. Dans le cas du choléra des poules Pasteur, Roux et Duclaux (1879) découvrent
que l'injection d'une culture vieillie du microbe (maintenant appelé Pasteurella avicida) protège les animaux de l'infection.
On raconte qu'au départ en vacances Pasteur aurait chargé Chamberland de repiquer régulièrement la souche bactérienne, ce qu'il aurait
négligé. Au retour de vacances les inoculations auraient donc été faites avec des bactéries affaiblies. De là serait né le concept
de l'atténuation de la virulence. Dans le cas du charbon, Pasteur obtient un vaccin en cultivant le bacille à 42° pendant 8 jours,
exploitant en cela les travaux d'un jeune vétérinaire, Jean-Joseph Toussaint, qui chauffait le sang d'un animal infecté à 55° en
présence d'un antiseptique et qui l'inoculait ensuite à un animal sain pour le protéger.
Pourquoi voyons-nous maintenant (fig 28) la belle grande toile de Renoir le déjeuner des canotiers, hymne à la beauté et à la joie de
vivre ? C'est parce qu'elle date de 1881*, l'année même où Pasteur a son premier contact avec la rage à la suite de la mort d'un enfant
mordu.
*1881 c'est aussi l'année de la création à Vienne de la 4ème symphonie de Brückner dite romantique et celle de naissance de Bela Bartok, le compositeur qui renouvellera la production musicale avec ses œuvres pour piano et ses œuvres orchestrales dont la crépusculaire musique pour cordes, percussions et célestat.

Fig 28 : Pierre-Auguste Renoir : le déjeuner des canotiers
Pasteur soudain pensif
Monsieur le delftois, bien que l'impressionnisme n'ait pas été ma tasse de thé, la belle toile de Renoir que vous évoquez me ferait
presque regretter de ne pas avoir choisi la peinture. mais revenons à nos moutons que j'ai protégé du charbon. Sachez que vous me
faites bien rire quand vous citez les travaux de ceux que vous appelez mes prédécesseurs, la plupart de ces travaux étaient incomplets,
sujet à maintes critiques et les vaccins inefficaces ! Mais c'est avec mes travaux sur la rage, monsieur le drapier, que j'ai fait la
démonstration de ce que doit être un vrai vaccin pour éradiquer une cruelle maladie, car vous ne contesterez pas que la rage était une
cruelle maladie qui répandait l'effroi. Et par la suite ce sont l'hygiène et les vaccinations qui ont évité les grandes épidémies.
C'est en effet la vaccination contre la rage qui allait rendre Pasteur célèbre.
La rage était relativement rare mais toujours mortelle lorsqu'elle était déclarée. Dans ses premiers essais, Pasteur inocule des lapins
avec la salive d'un enfant mort de la rage. Les lapins meurent mais d'autres maladies que la rage : la salive ne contenait peut-être
pas l'agent de la rage mais d'autres bactéries pathogènes. Comme l'agent de la rage est un virus indécelable en microscopie optique,
Pasteur n'a jamais pu le voir.
En désespoir de cause, pour vacciner, il applique sa méthode d'atténuation de la virulence inaugurée avec le choléra des poules. Pour
cela des fragments de moelle épinière de lapins enragés sont conservés dans des flacons contenant un agent desséchant ce que lui avait
suggéré Roux (fig 29 : toile de 1865 du peintre finlandais Edelfelt (1854-1905) montrant Pasteur examinant un fragment de moelle dans un
flacon contenant de la potasse, Musée d'Orsay, Paris). La virulence du "virus" diminue avec la durée de conservation des fragments. Les
extraits des fragments servent à préparer le vaccin. Celui-ci s'applique en inoculations successives apportant chacune un extrait de
moelle conservée pendant des durées de plus en courtes, c'est-à-dire apportant un "virus" de plus en plus actif.
Le coup de maître est la guérison du petit Joseph Meister (1885), mais il n'est pas certain que le chien était enragé. Après la guérison
du berger Jupille qui avait défendu plusieurs enfants contre un chien enragé, Pasteur put faire état d'un nombre impressionnant de patients
guéris (830 en 3 mois). Le nombre des cas de rage augmentaient dans des proportions considérables si bien qu'un détracteur de Pasteur,
le docteur Lutaud, pouvait dire qu'avec « 4000 cas pendant l'année on serait tenté de croire que les gens deviennent enragés à
plaisir depuis qu'on leur offre une certitude de guérison » .
La publicité, organisée par Pasteur, va perpétuer l'image du bon savant vainqueur de la rage. Une photographie montre Pasteur, entouré
de jeunes enfants guéries de la rage. Les travaux sur la rage sont diffusés à l'étranger et après la guérison de Joseph Meister la
notoriété de Pasteur devient mondiale


Fig 29 : l'examen Fig 30 : les fameux moujiks
Les travaux de Pasteur, pas plus que ceux de Koch, n'avaient eu beaucoup de retentissement aux Etats-Unis jusqu'au 4 Décembre 1885 quand
le Hérald titre « Sous la terreur de l'hydrophobie six enfants de Newark mordus par un chien présumé enragé, Pasteur appelé à
l'aide, une tentative est faite pour envoyer les enfants à Paris ». Dès lors on organise une souscription et tous les journaux
décrivent les garçons et leur famille embarquant sur un transatlantique pour le Havre. Les enfants arrivent en France et le traitement
commence. Un hebdomadaire, le magazine Puck, publie en double page et en couleur un dessin humoristique avec la légende : « C'est
maintenant le moment d'être mordu par un chien enragé et de faire un voyage à Paris » (sous-entendu aux frais de la collectivité).
Des moujiks (fig 30) viennent également subir le traitement antirabique à la suite de morsures par un loup. On les voit traverser la rue
Lhomond pour se rendre au laboratoire de la rue d'Ulm où ont lieu les vaccinations antirabiques. Mais le traitement n'est pas toujours
couronné de succès : ainsi, selon Léon Daudet, dans ses souvenirs des milieux littéraires, politiques, artistiques et médicaux de
1880 à 1905, parmi les 19 Russes venus se faire soigner, certains développèrent la maladie et accusèrent de telles souffrances que
Pasteur, parait-il, consentit à leur euthanasie. En vérité il semble que la vaccination ait entraîné de nombreux décès, peut-être plus
de 70 connus en 1886, soit en présentant les symptômes de la rage soit ceux d'une affection nouvelle que l'on dénomma rage des
laboratoires.
Monsieur Pasteur, je reconnais vos mérites concernant les vaccinations et je salue votre courage, votre ténacité, voire votre témérité,
dans le cas du vaccin contre la rage car vous n'aviez que deux fois expérimenté sur l'homme avant de traiter le jeune Meister. Mais je
dois dire, alors que vous m'avez accusé de m'être fait de la publicité, qu'une partie de votre gloire tenait à votre capacité à vendre
vos trouvailles. La modestie n'était pas votre fort et votre désir de gloire si grand que vous lui avez parfois sacrifié la vérité. La
vérité c'est qu'il y a eu des morts dus au vaccin, peut-être plus qu'on ne le croit mais il est vrai que l'on ne fait pas d'omelette
sans casser d'œuf !!!! Néanmoins je ne peux oublier que, quand cela vous servait, vous ne vous appliquiez pas la rigueur que vous
imposiez aux autres.
Vos critiques, Monsieur Leeuwenhoek, ne sont que des ragots de minables, jaloux de mes réussites. Pour moi ne compte que l'image que je
laisse dans l'histoire : un grand savant, génial et bienfaiteur de l'humanité.
Je ne veux point aller plus loin dans ce débat que l'histoire a déjà jugé, Monsieur Pasteur. Vous êtes satisfait de votre parcours de
grand savant, néanmoins vous avez bien du avoir quelques frustrations : par exemple ne pas avoir vu le microbe de la sinistre rage ?
Oui, je parlais de "virus" mais au fond j'ignorais ce que c'était, voyez-vous j'avoue mes ignorances.Mais souvenez-vous mon cher
Leeuwenhoek : ce sont des botanistes qui ont les premiers mis en évidence ces fameux virus.
La découverte des virus
Dans ses travaux Pasteur parlait de virus rabique, la rage n'était pas due en effet à une bactérie mais à une entité plus petite qui
traversait les filtres en porcelaine mis au point par Chamberland. Chamberland qui, associé à beaucoup de travaux de Pasteur, a non
seulement fabriqué ces filtres si importants pour la mise en évidence des virus mais aussi perfectionné l'autoclave qui dérivait des
travaux sur la stérilisation des aliments de Nicolas Appert, l'inventeur du bouillon cube.
La découverte des virus* fut plutôt laborieuse. D'abord non seulement on ne les voyait pas au microscope mais ils n'étaient pas
cultivables sur les milieux propices à la croissance des bactéries. On doit à Ivanovski et à Beijerinck d'avoir clarifié le problème des
virus
*Un moment, après la découverte des toxines solubles comme celle de la diphtérie par Roux et Yersin (1888) certains assimilèrent ces "virus filtrants" à des toxines. Malheureusement on constata vite que des virus inoculés se multipliaient dans l'hôte, comme dans le cas de la fièvre aphteuse (Loeffler et Frosch, 1897), ce que ne font évidemment pas des toxines.
Cette belle toile de Corot, le Souvenir de Mortefontaine, date de 1864*, l'année même de la naissance d'Ivanovki. Corot a plus de cinquante ans, il a perdu ses parents et pour lui le monde s'éloigne déjà dans les lointains de la mémoire, Corot reste seul face à ses souvenirs.
*Et la même année la Petite messe solennelle de Rossini est créée à Paris ; c'est aussi l'année de l'opéra bouffe La belle Hélène, d'Offenbach, qui ridiculise la vie bourgeoise de la cour de Napoléon III.

Fig 31 : Souvenir de Mortefontaine Huile/toile, 1864, Musée du Louvre
Dmitri Losifovich Ivanovski (fig 32) est né en 1864 près de Saint-Pétersbourg. Après de brillantes études, au contact de maîtres éminents comme Mendeleiev, le classificateur des éléments chimiques, il devient botaniste. Très tôt, il s'intéresse à la mosaïque du tabac (fig 33). Après l'introduction du tabac* en France par jean. Nicot, ambassadeur de France à Lisbonne, qui en offrira à Catherine de Médicis sous forme d'une poudre dont elle se servait, parait-il, pour soulager ses migraines, la culture de cette plante s'était répandue dans toute l'Europe et en particulier en Hollande et en Russie.
*Le tabac (Nicotiana tabacum et espèces voisines) est originaire d'Amérique. Les espagnols le découvrent en 1498 en abordant l'ile de Tobago (d'où tabac) dans les Caraïbes. L'herbe fût retrouvée au Brésil et rapportée au Portugal.
Dans la mosaïque du tabac les feuilles présentent des alternances de plages bien vertes et de plages entièrement décolorées. Au cours de ses travaux dans le sud de la Russie, Ivanovski étudiant des plants malades, fait la distinction entre l'atteinte par une rouille et la mosaïque, les deux maladies pouvant atteindre un même pied. La rouille est peu contagieuse à la différence de la mosaïque (ce qu'avait également montré un hollandais, Mayer). En 1892 Ivanovski montre que la sève des plantes malades conserve son caractère infectieux lorsqu'elle est filtrée sur bougie de Chamberland, cependant il pensa qu'il s'agissait d'une toute petite bactérie.
*Les rouilles sont des maladies cryptogamiques des plantes vasculaires dont les agents pathogènes responsables sont des champignons basidiomycètes (Fungi,anciennement Uredinales).Ces champignons phytopathogènes sont des parasites obligatoires biotrophes ne pouvant se développer que sur un végétal vivant et dont les espèces sont hautement spécialisées. Elles se manifestent par des taches ou des pustules apparaissant sur les feuilles. Le cycle de vie de ces champignons est complexe. Deux rouilles ont été signalées sur tabac. Puccinia substriata, (Puccinia substriata Ellis & Barthol, (1897) var substriata), qui sévit essentiellement au Honduras. La seconde rouille, plus largement répandue, a été rapportée au Brésil, en Amérique Centrale, au Zimbabwe et en Italie: Uredo nicotianae Anastasia, Sacc. & Splend. (1904). Ces deux rouilles, ne sévissent pas en France.



Fig 32 : Ivanovski Fig 33 : mosaïque du tabac Fig 34 : Beijerinck et quelques galles
Mais c'est Martinus Willem Beijerinck (1851-1931) (fig 34) qui précisa ce concept de virus. Fils d'un tenancier de débit de tabac (un
bel argument pour s'intéresser à la mosaïque) diplômé de l'Institut polytechnique de Delft, il devient assistant de botanique à Utrecht
puis à Wageningen et enfin professeur de bactériologie à Delft. Ses travaux furent très nombreux (plus de 140 articles) ; ils portaient
sur des sujets aussi différents que l'origine des galles, la bactériologie du sol, la nutrition des bactéries. En 1897, il vérifie les
observations d'Ivanovski et montre que la mosaïque n'est pas due à un microbe mais à un principe vivant fluide qui franchit
les bougies filtrantes et diffuse dans la gélose. Ce "principe" ne se développe que dans les tissus jeunes, riches en divisions
cellulaires. Il est inactivé par l'ébullition mais résiste à la dessication. Ses conclusions sont rejetées par la majorité des
bactériologistes de l'époque, elles sont pourtant proches du concept moderne de virus.
Voir le virus.
Avec le microscope électronique (introduit en 1930-1940) on a pu voir le virus de la mosaïque du tabac (fig 35). C'est une sorte de
cylindre, la partie centrale est occupée par un filament hélicoïdal d'acide nucléique, c'est le génome du virus. Celui-ci est enveloppé
par des unités protéiques. Le virus de la rage (fig 36) ressemble un peu à celui de la mosaïque. Mais d'autres virus ont des formes
très différentes.





Fig 35 : mosaïque Fig 36 : virus rabique Fig 37 : bactériophages Fig 38 : coronavirus Fig 39 : ébola.
Ainsi certains évoquent de petits modules que l'on destinerait à l'exploration lunaire : ce sont des virus de bactéries, des
bactériophages (fig 37), D'autres virus sont sphériques, comme les virus de la grippe ou les coronavirus des covids (fig 38), d'autres
enfin sont filiformes, c'est le cas du virus Ebola (fig 39). Les virus ne contiennent qu'un seul acide nucléique : ribo (ARN) ou
désoxyribonucléique (ADN) ; ils ne peuvent se multiplier que dans une cellule : ce sont des parasites obligatoires.
Mais les choses étaient trop simples car depuis on a trouvé des virus aussi grands que des bactéries, comme le Mimivirus* à ADN, merci
Didier Raoult. On a également trouvé des entités constituées uniquement d'ARN : les viroïdes** identifiés la première fois en 1971 par
Théodor Diener dans une maladie de la pomme de terre. Eux sont tout petits (50 nm), et connus uniquement chez les plantes (pour le
moment !), ils sont répliqués comme les autres virus dans une cellule hôte (copie dans le nucléole ou les chloroplastes). En revanche
les ribozymes qui catalysent des réactions chimiques (ribosomes) existent aussi chez les animaux, leur découverte a donné naissance à
une théorie sur l'origine de la vie, un monde ARN, la molécule d'ARN étant à la fois catalyseur de réactions et porteuse d'une
information génétique.
Mais il existe aussi des particules protéiques pathogènes, comme l'agent de la tremblante du mouton (travaux de Stanley Prusiner,
Nobel 1997), du kuru, de la maladie de la maladie de Creuzfeld-Jacob ou de la vache folle. Ces particules, les prions, sont des
protéines (PrPSc) correspondant à des protéines normales du neurone (PrPC) mal repliées. Ils se forment spontanément ou par mutation,
sont transmissibles et provoquent la transformation des protéines normales et la formation de plaques dans le cerveau. Les prions sont
les agents des encéphalopathie spongiformes des animaux et de l'homme.
*Pour mimicking microbe virus, officieusement souvenir de son enfance et des aventures de Mimi l'amibe
**les virusoïdes sont des particules sub-virales d'ARN circulaire simple brin tributaires des viroïdes (phytovirus) pour leur
réplication. Les ARN satellites sont des pathogènes des animaux qui peuvent coder pour des protéines mais comme les virusoïdes ils
doivent être en co-infection avec un virus pour se répliquer dans la cellule. Le virus de l'hépatite delta (HDV) comporte un ARN de
grosse taille codant pour les protéines HDV. Le virus auxiliaire est celui de l'hépatite B. La coinfection provoque une atteinte
hépatique plus grave que la B seule.
En brassant ses souvenirs Pasteur devient nostalgique
Ah mon cher Leeuvenhoek, d'évoquer toutes ces connaissances me rend tout chose, quels efforts, quelle ténacité ont déployés ces
chercheurs pour obtenir des résultats originaux, un brin de gloire voire un Nobel, prix qui n'existait pas à mon époque, mais que de
joies simples, de petits bonheurs familiaux, d'enrichissements culturels sacrifiés à cette science, amante exigeante et cruelle. Et que
de douleurs, que de deuils, la perte d'un enfant, la maladie subite, des douleurs qu'il faut surmonter pour continuer son œuvre. J'ai
connu cela Monsieur Leeuwenhoek, j'ai connu cela !
Pasteur a presque la larme à l'œil !
Je sais, Monsieur Pasteur, je sais combien vous avez souffert de la perte de trois de vos filles, terrassées par la typhoïde ou une
horrible tumeur du foie. Je sais comment vous avez dominé l'hémiplégie qui avait fait redouter le pire, je sais combien vous avez lutté
contre l'adversité pour faire progresser la science. Et pourtant malgré de tels sacrifices, rares cependant sont ceux dont le nom reste
dans l'histoire, comme vous.. et moi ! Comme petit drapier je ne suis pas mécontent d'avoir ainsi apporté ma petite pierre à l'édifice
que vous avez plus tard nommé Microbiologie.
Oui, Monsieur Leeuvenhoek, par mon œuvre la notion de microbe s'est clarifiée et j'ai montré l'intérêt de ces microorganismes en
médecine mais aussi dans bien d'autres domaines. Et pour cela j'ai du batailler avec des illuminés comme ce Béchamp, professeur à
l'université de Montpellier, et ses adeptes qui prétendaient que les microbes étaient « un processus provenant d'une souche unique :
les microzymes qui pouvaient changer de dimensions et de forme selon les organismes dans lesquels ils vivaient ».
Il est vrai que Pasteur a discrédité la théorie de Béchamp qui ne résistait pas à une analyse expérimentale sérieuse qui montre
l'immense diversité des microorganismes. Cette diversité, la Microbiologie en rend compte.
Alors, au fond, la microbiologie qu'est-ce que c'est ?
Pour faire simple, c'est la science qui décrit les êtres microscopiques. Tout d'abord des cellules à noyaux qui vivent libres. Dans ces
cellules on retrouve les acides nucléiques, ADN et ARN, qui caractérisent les êtres pluricellulaires. C'est le cas de ces levures
(fig 40) qui réalisent des processus fermentaires comme la fermentation alcoolique. C'est le cas de cette belle microalgue (fig 41)
dont la couleur verte est due à un chloroplaste, petit organite chlorophyllien. C'est également le cas des infusoires (fig 42 et 43)
qui ont été découverts par Leeuwenhoek.




Fig 40 : Saccharomyces Fig 41: Micrasterias Fig 42 : vorticelles Fig 43 : paramécie

Fig 44 : Y.pestis, colonies et vue en me. Fig 45: E.coli, me Fig 46: microbiote, me
Mais la microbiologie s'intéresse également à des cellules dépourvues de noyau, comme ce bacille de la peste Yersinia (fig 44, colonies
et vue en microscopie électronique, me), cet Escherichia coli (fig 45, me) observé dans une goutte de sang ou ces nombreuses bactéries
du microbiote intestinal (fig 46, me). Bien que dépourvues de noyaux, les bactéries comportent néanmoins les deux acides nucléiques :
ADN et ARN.
La microbiologie recouvre aussi la virologie. Dans le cas des virus on ne peut parler de cellule, on les place dans l'ensemble des
"organismes acellulaires". Les virus ne sont pas vivants au sens habituel du terme, ce sont des parasites obligatoires qui doivent être
hébergés dans une cellule vivante pour se multiplier. Leur génome, qui ne comporte qu'un seul acide nucléique (ADN ou ARN), est
comparable à un compact disque qui ne peut exprimer son message que s'il est lu dans un lecteur : ce lecteur c'est la cellule vivante.
Mais on a vu la grande variété des entités classés dans cet ensemble acellulaire.
Au cours du temps les microbiologistes ont découvert les microbes dans tous les milieux, dans les eaux et dans les milieux fermentaires
si utiles pour l'alimentation de l'homme. Ils en ont trouvé sur sa peau qu'ils protègent et dans son intestin (le fameux microbiote)
mais aussi dans toutes sortes de maladies qui l'atteignent. Ils les ont trouvés dans les milieux les plus extrêmes : le fond des océans
avec les fumeurs noirs *(fig 47), dans des effluves volcaniques des solfatares (fig 48), à des température très basses ou au contraire
très élevées, quelques 200 degrés.
*Les fumeurs noirs sont des sortes d'évents hydrothermaux, sorte de cheminées de plusieurs dizaines de m d'où sort une eau chaude à 300°. Ils sont situés sur les dorsales océaniques au niveau des affrontements de plaques, un peu comme les volcans. Ils évacuent la chaleur interne. Leur couleur est due à des sulfures de fer et de manganèse. Mais cette eau chaude est riche en composés minéraux et à proximité vit un écosystème comprenant des microorganismes lithotrophes, fabriquant leur énergie par oxydation de composés inorganiques (soufre, fer ferreux, hydrogène sulfuré..). Certains supportent de très hautes températures. On trouve des animaux : des vers comme les fameux Riftia, des crustacés, des poissons. L'oxydation du sulfate ferreux donne du sulfate ferrique, 2 hydrogènes (H) et 2 électrons. Cette réaction serait la source d'énergie et de pouvoir réducteur nécessaire à la vie hydrothermale, H et le gaz carbonique permettant la synthèse des molécules organiques.


Fig 47 : fumeur noir Fig 48 : solfatare
Chez les plantes, comme chez l'animal, les bactéries sont parfois utiles, parfois pathogènes (phytopathologie). Ainsi des bactéries du genre Rhizobium favorisent le développement de légumineuses. Ce sont des bactéries du sol qui pénètrent dans les tissus de la racine, donnent des nodosités (fig 49) et s'y transforment en bactéroïdes qui fixent l'azote de l'air. Il se réalise une symbiose (cohabitation à avantages réciproques), la plante permettant la nutrition carbonée de la bactérie et cette dernière lui fournissant un supplément de composés azotés.



Fig 49 : nodosités de Rhizobium Fig 50 : balai de sorcière Fig 51 : Crown-gall
Mais d'autres bactéries sont pathogènes. Certaines bloquent les vaisseaux qui transportent la sève, d'autres provoquent des pourrissements, d'autres perturbent l'équilibre des hormones du végétal (formation de balais de sorcière par exemple, fig 50) d'autres enfin provoquent des tumeurs analogues à des cancers (crown-gall*, fig 51).
*Le crow-gall ou galle du collet était connu depuis l'antiquité mais l'agent causal n'est découvert qu'en 1907 par deux chercheurs américains, E.F.Smith et C.O.Townsend, qui le nomment Bacterium tumefaciens (on le nommera plus tard Agrobacterium tumefaciens). Ce n'est qu'en 1940-42 que l'on démontre le caractère cancéreux de ce processus tumoral (P.R.White et A.C.Braun). que ces auteurs expliquent par la présence dans la plante d'un principe inducteur de tumeur apporté par la bactérie. A la suite de cette découverte, le crown-gall devient l'objet de nombreux travaux parce qu'il représente un modèle de cancérisation apparemment simple. Au cours du temps, entre 1950 et 1975, on invoque plusieurs hypothèses sur la nature du principe inducteur : toxine, virus, fragment d'acide nucléique. Finalement en 1977 Nester et ses collaborateurs démontrent que le principe inducteur est un petit ADN circulaire qu'ils nomment T.DNA, De petits ADN circulaires sont fréquents chez les bactéries, on les nomme plasmides. Grace au génie génétique, on a pu ajouter à ce T-DNA des gènes d'intérêt et les introduire dans des tissus végétaux grâce à l'Agrobacterium, obtenant ainsi des organismes génétiquement modifiés (OGM) : fruits à maturation retardée, plantes résistant à des herbicides ou à la sécheresse. Mais la découverte des mécanismes d'incorporation de fragments nucléiques dans le génome cellulaire a aussi permis de comprendre le mode d'action de certains virus (les rétrovirus) comme celui du SIDA.
Finalement, Monsieur Pasteur, si je compte bien, il aura fallu quatre siècles de recherches pour découvrir et comprendre ce que sont
les microorganismes et combien ils interviennent dans la nature et la vie de l'homme. C'est à vous, et à moi, à vos collaborateurs et
à vos successeurs, Monsieur Pasteur, mais aussi à combien d'autres qu'on le doit. Lorsqu'en 1888 vous avez introduit le terme de
microbiologie vous avez créé une nouvelle science autonome des êtres microscopiques, recouvrant à la fois leur morphologie, leur
physiologie et leur génétique. En France au moins, où vous êtres une gloire nationale, on ne peut évoquer les microbes sans vous citer,
Monsieur Pasteur. En 2022 on a fêté le bicentenaire de votre naissance.
1822, cette année-là, un grand peintre anglais, Constable, exposait ses premières études de nuages (fig 52). Le ciel anglais
prenait une place essentielle dans l'œuvre de ce précurseur de l'impressionnisme. Entre 1821 et 1822 il produit une centaine d'études
de ciel dont certaines très travaillées deviennent des œuvres à part entière.


Fig : 52 : John Constable (1776-1837), études de nuages
Mais ce qui m'interroge, Monsieur Pasteur, c'est que dans tous vos travaux vous semblez ignorer le grand Darwin qui montrait (1859), au
moment où vous vous opposiez à Pouchet, que la vie évolue et que chaque être est au fond le produit du hasard et de la nécessité comme
dira plus tard un de vos lointain élève, le célèbre Jacques Monod. Et que cela a remis en cause bien des croyances et changé
l'interprétation du monde vivant. Comment l'avez-vous ressenti comme fervent catholique ?
En effet l'évolution des espèces n'a pas été seulement un problème scientifique mais elle a suscité des débats d'ordre philosophique,
religieux et politique.
Qui dit évolution dit changement progressif. Aussi l'idée d'évolution est-elle indissolublement liée à celle de transformation. La
transformation parait s'opposer à la fixité des espèces telle qu'on l'observe. Pourtant l'idée évolutionniste prend en compte ces deux
aspects de la vie des espèces : leur conservation et leur transformation. Elle s'oppose à la notion de création divine, ce qui ne
pouvait que heurter Pasteur.
Déjà, dès la Renaissance, l'adoption de la méthodologie scientifique avait amené plusieurs savants de l'époque à contester le
créationnisme. C'était le cas de Cardan (1501-1576), un savant d'origine italienne, surtout connu pour ses travaux en mathématiques,
qui indiquait que les espèces se modifient au cours du temps. C'était le cas de Vanini (1585-1619) qui prétendait deux siècles avant
Darwin que l'homme descend du singe et qui pour cette raison finira en barbecue sur une place publique de Toulouse après qu'on lui eut
arraché la langue. C'était le cas de Giordano Bruno (1548-1600), un dominicain rebelle, qui croyait en un univers infini et qui fût
supplicié pour hérésie. Vanini et Bruno ont été suspectés d'être les auteurs du traité anonyme dit des trois imposteurs qui
reprenait une vieille histoire qui circulait depuis l'an 1200. On y accusait Moïse, Mahomet et Jésus Christ d'être trois imposteurs qui
ont dupé le monde, Jésus Christ n'aurait été qu'un philosophe et un politique.
Au XVIIIème siècle, Buffon (fig 53) est probablement celui des naturalistes de l'époque qui a le plus alimenté l'idée transformiste.
Comme intendant du jardin du Roi (de 1739 à 1788), il décrit de nombreuses espèces d'animaux et de végétaux. Il insiste sur la
variabilité au sein de l'espèce « Et de même de tous les animaux, le chien est aussi celui dont la nature est la plus sujette à
variété. Le tempérament, les facultés, les habitudes du corps varient prodigieusement.il n'est pas moins évident que tous les chiens,
quelques différents qu'ils soient, ne font qu'une seule et même espèce. »



Fig 53 : comte de Buffon Fig 54 : ammonites Fig 55 : Maupertuis
A la même époque certains invoquaient l'existence des fossiles (fig 54), des coquilles et des os présents dans des terrains anciens,
pour justifier leur ralliement à l'évolutionnisme.. Voltaire vient mettre son grain de sel dans ces histoires de coquilles : dans
les singularités de la nature de 1768 son esprit caustique ridiculise l'utilisation que l'on peut faire des fossiles pour prouver
l'évolutionnisme. Il écrit :
« On trouve dans quelques endroits de ce globe des amas de coquillages ; de là on conclut que malgré les lois de la gravitation
et celles des fluides et malgré la profondeur du lit de l'océan, la mer avait couvert toute la terre il y a quelques millions d'années.
Si la mer a été partout, il y a eu un temps où le monde n'était peuplé que de poissons .. enfin les poissons sont devenus des hommes ;
et tout cela s'est fait en conséquence des coquilles qu'on a déterrées. Ces systèmes valent bien l'horreur du vide, les formes
substantielles, la matière globuleuse.la baguette divinatoire de Jacques Aimard..et le mouvement perpétuel. »
Mais Voltaire fait fausse route car les preuves à l'évolutionnisme s'accumulent, certaines sont dues à Pierre Louis Moreau de Maupertuis
(1698-1759, fig 55) un brillant géomètre, philosophe et naturaliste breton. Après un bref passage dans le corps des mousquetaires, il
se livre à des études en mathématique. Il dirige aussi une expédition en Laponie en 1736-37 pour déterminer la longueur d'un arc de
méridien polaire. En mécanique, on lui doit le principe de moindre action. Suite à une querelle à propos de ce dernier, il se brouille
avec Voltaire. Celui-ci le ridiculise sous le sobriquet de docteur Akakia.
Mais ce docteur Akakia avec ses ouvrages, La vénus physique et La dissertation à l'occasion d'un nègre blanc, est un
précurseur de la génétique. Maupertuis élevait des chiens et des volailles de races diverses et faisait des expériences d'hybridation.
Il reconnaît la variabilité au sein des espèces « nous voyons apparaître des races de chiens, de pigeons, de serins qui n'étaient
point avant dans la nature. Ce n'ont été d'abord que des individus fortuits, l'art et la génération en ont fait des espèces » .
Pour lui, ces variations sont la conséquence de modifications durables dans les semences mâle et femelle, elles se feraient au hasard
mais ne subsisteraient que les combinaisons favorables. On trouve donc déjà chez Maupertuis les idées de mutation et de sélection
chères aux évolutionnistes.
Bien d'autres après lui vont apporter des preuves de cette évolution comme Lamarck et Geoffroy Saint- Hilaire. En revanche le père de
la paléontologie, le célèbre Cuvier est très opposé au transformisme : il empêchera même l'accès de partisans de cette théorie à des
carrières académiques et à la mort de Lamarck (1829) il composera un éloge funèbre tournant en ridicule les idées transformistes de
celui-ci. C'était très vilain !!
Mais c'est à Charles Darwin (1809-1888, fig 56) que revient le mérite de faire la synthèse de tous ces travaux et de les compléter par
ses propres observations lors du fameux voyage autour du monde du Beagle (fig 57).
Ainsi au cours de ce voyage, lorsque Darwin arrive à l'île Chatham, une des îles des Galapagos, au large de l'Equateur, il observe en
particulier les pinsons (fig 58). Dans les îles on trouve quatorze variétés différentes de pinsons. Les pinsons des îles ressemblent à
ceux du continent américain voisin. Cependant chaque variété de pinson présente des traits spécifiques, par exemple la forme du bec. Or
le gouverneur des îles avait fait remarquer à Darwin que chaque variété provenait d'une île différente. Au retour de son voyage, Darwin
confie les spécimens d'animaux rapportés à plusieurs spécialistes dont John Gould pour les oiseaux. L'expertise ornithologique prouve
que les variétés de pinson sont en fait de véritables espèces. Darwin en tire alors à l'idée que les pinsons ont colonisé les îles à
partir du continent mais que les conditions particulières à chaque île ont déterminé les différences propres à chaque espèce. En
particulier la forme du bec s'est modifiée en fonction du type de nourriture disponible : bourgeons et fruits, insectes ou graines.
Cette étude devient alors un des piliers classiques de la théorie darwinienne exposée dans L'origine des espèces de 1859.



Fig 56 : C.Darwin Fig 57 : le Beagle Fig 58 : les becs des pinsons
Mais en 1871 Darwin publie aussi L'ascendance de l'homme et la sélection sexuelle, un de ses ouvrages fondamentaux. Il montre
que l'homme est une espèce comme une autre mais que ses caractéristiques biologiques et ses comportements le rapprochent des singes.
En Angleterre et en Amérique l'opposition fût sérieuse. On raconte un échange acerbe entre l'évêque d'Oxford et Huxley, un ardent
défenseur de l'évolutionnisme que l'on baptisait le bull dog de Darwin
« Est-ce du coté de votre grand-mère ou de votre grand-père que vous prétendez descendre du singe » demande l'évêque ?
« Je préfère avoir un singe pour grand-père plutôt qu'un homme richement doué qui se montre aussi ignorant » répond
Huxley. En dépit de ces controverses à la fin du XIXème siècle le Darwinisme a triomphé. En France, où la résistance dura plus que de
raison, certains partageaient l'opinion de. Bernard Shaw qui disait « une mare d'amibes, avec le temps, devient l'Académie
française » .
Mais dans un autre ouvrage Darwin traite de la sélection sexuelle. Bien que d'abord scientifique le livre ne pouvait ignorer les
aspects philosophiques, voire politiques et par là engendrer des débats encore plus houleux que ceux qu'avait suscités l'origine
des espèces. Cette sélection sexuelle elle avantage certains individus en ce qui concerne la reproduction. La rivalité entre mâles
pour la possession des femelles et le choix exercé par celles-ci jouent un rôle important (l'homme propose.la femme dispose). Il en
résulte une multitude de comportements selon les espèces conduisant parfois à des effets anti-adaptatifs comme la parure de noce de
certains oiseaux mâles, tels les paons, qui les empêche presque de voler et les rend vulnérables aux prédateurs.
A la suite de Darwin les éthologues ont montré une grande diversité dans les comportements sexuels dont l'intérêt évolutif est
extrêmement variable. Ainsi les oiseaux sont en général fidèles mais, dans une population déficitaire en mâles, la fidélité est
désavantageuse pour l'espèce. En revanche, les chats, comme beaucoup d'autres mammifères, sont infidèles, à l'exception de l'homme bien
sûr. On connaît l'homosexualité chez beaucoup d'espèces du lamantin aux oies sauvages en passant bien sûr par le phoque. On n'en a pas
encore parlé chez les dinosaures, mais cela viendra ! Ce comportement marginal se trouve justifié en cas de pénurie en femelles mais il
ne saurait assurer la perpétuation de l'espèce. Les liens sociaux construits par les pratiques sexuelles et une grande part de
l'homosexualité animale contredisent la plupart des fondements du néodarwinisme.
Monsieur Leeuwenhoek, je n'ai pas plus rencontré l'évolution dans mes travaux que vous dans les vôtres. Et ceux des évolutionnistes ne
sont pas très sérieux : de la girafe qui se pousse du col pour atteindre les hautes branches aux soi-disant mutations observées par de
Vries ou plus tard sur les petites mouches du vinaigre, que de recherches pour prouver quoi ? que l'homme descend du singe ?? Des
évolutionnistes eux-mêmes l'admettent la théorie pose plus de questions qu'elle n'en résout : les transformations sont-elles
véritablement graduelles ? or il existe des mutations brusques et héréditaires, qu'elle en est l'origine ? et comment s'opère leur
transmission à la descendance, ce qui soulève le fameux problème de l'hérédité des caractères acquis et bien d'autres questions encore.
Théories, Monsieur Leeuwenhoek, tout cela n'est que théories et rien que des théories !
Monsieur Pasteur vous devriez savoir que certaines de ces questions trouvent déjà leurs réponses dans les travaux de Haeckel, Weismann,
De Vries et Grégor Mendel.
J'aime bien Haeckel, il portait grande attention aux microorganismes dont il faisait de fort beaux dessins et j'aime bien ce vieux
Mendel, bien qu'il se soit écarté de la religion avec son horrible loi des petits pois comme disaient les tenants du communiste
Lissenko...
Haeckel (1834-1919) (fig 59) était un médecin, biologiste et libre penseur. Vers 1866 il popularise la théorie de l'évolution en
Allemagne et crée même une véritable religion de la science qui fera de nombreux adeptes. Au cours de ses voyages, il décrivit des
centaines de nouvelles espèces portant effectivement son attention sur des organismes microscopiques (fig 60) mais aussi les éponges,
les méduses et toutes sortes d'animaux marins (fig 61). Certains de ses ouvrages, comme Kunstformen der Natur, les formes de la
nature, présentent des illustrations véritablement artistiques. Quant à August Weismann (1834-1914,fig 62), naturaliste allemand,
il élabore la théorie de la lignée germinale qui postule l'indépendance des cellules sexuelles, le germen, et des cellules
du corps, le soma. Il a également réfuté la transmission des caractères acquis que Darwin admettait implicitement.
Pour faire la démonstration il entreprend en 1887 une expérimentation qui durera plus de 2 ans. Il élève des couples de souris dont il
coupe la queue, voilà le caractère acquis : l'absence de queue (en fait c'est plutôt un caractère disparu !!!). Ces souris sans queue
donnent des portées successives de souriceaux dont on coupe également la queue et ainsi de suite. Si bien qu'en 1889 Weismann avait
observé plus de 900 souris nées de parents sans queue ; aucune n'était née sans queue ou avec une queue rudimentaire. L'expérience
s'arrêta parce qu'à la 6ème génération des individus à queue coupée demeurèrent stériles.




Fig 59 : Ernst Haeckel Fig 60 : microalgues Fig 61 : ascidies Fig 62 : A.Weismann
On aurait pu conclure de cela que les souris, écœurées par cet équeutage répétitif, avaient perdu leur libido ou bien que l'absence de queue conduit à la longue à la stérilité. Mais Weismann préféra affirmer que les caractères acquis ne se transmettent pas à la descendance. Weismann n'avait pas pour autant réglé définitivement le problème de l'hérédité des caractères acquis, ce dont il était bien conscient. Ce problème resurgit en URSS entre 1930 et 1960 sous l'influence néfaste de Trofim Lyssenko*, un agronome ukrainien. Mais depuis la découverte des modifications épigénétiques, non portées par des gènes, l'existence de certains caractères acquis héréditaires est maintenant prouvée.
*Lyssenko s'était fait un nom en introduisant la vernalisation qui permet de transformer un blé d'hiver en blé de printemps. Il entre en conflit à ce sujet avec les généticiens russes, mais la Pravda prend fait et cause pour Lyssenko. Bien dans la ligne du parti communiste, Lyssenko condamne l'horrible "loi bourgeoise des petits pois" et la "génétique mendélo-morganienne" réactionnaire.
En 1866, Gregor Mendel (1822-1884, fig 63), l'illustre moine de Brno, auteur des Recherches sur les hybrides végétaux*, pose les bases de la génétique moderne et introduit l'idée de particules héréditaires, les futurs gènes. C'est le père de la génétique dite formelle.
* Il semble que Mendel ait commencé à expérimenter sur des couples de souris mais cette débauche de copulations dans un monastère faisait mauvais genre, aussi son Supérieur lui conseilla de changer de matériel expérimental, Mendel choisit les petits pois.
Il faut attendre 1903 pour qu'on localise les gènes sur les chromosomes (W.S Sutton puis Morgan et son école,1910) et les premiers travaux de génétique des populations (de L'Héritier et Tessier,1933) pour que soit vérifié le gradualisme darwinien (au sein des populations les fréquences des gènes évoluent de façon continue). Mais beaucoup de résultats n'étaient pas en accord avec la théorie darwinienne, par exemple les mutations décrites par Morgan (1866-1945) chez la drosophile (fig 64) ne concernaient que des caractères discrets comme la couleur de l'oeil ou la longueur des ailes, ce qui pouvait difficilement expliquer l'apparition de nouvelles espèces. Aussi dans les pays anglophones apparaissent le néodarwinisme* et la théorie synthétique de l'évolution*.
*œuvres de T.Dobzansky (1900-1975) , J.S. Huxley (1887-1975), E.Mayr (1904-2005) et G. G. Simpson (1902-1984).


Fig 63 : G.Mendel Fig 64 : T.H Morgan ; mutations et chromosome de drosophile
Quelques grandes idées sous-tendent cette théorie : hérédité particulaire (gènes), pas de caractères acquis, modification graduelle des populations naturelles, importance de la sélection et des adaptations, une place importante est réservée au mécanisme de formation d'espèces par l'existence de barrières géographiques. Prenons le cas des écureuils (fig 65). Les écureuils américains et européens ont les mêmes ancêtres mais la population initiale s'est trouvée divisée en deux populations qui ont évolué indépendamment si bien que se sont constituées deux nouvelles espèces. Si on confronte maintenant les écureuils américains et européens ils pourront bien échanger des noisettes mais ne pourront pas s'accoupler. On a là deux espèces différentes qui ne peuvent s'hybrider.


Fig 65 : écureuils américain et européen
Pour les néodarwinistes la macroévolution, c'est-à-dire les grandes transformations qui donnent naissance à de nouvelles espèces, ne serait que la prolongation, avec le temps, des processus qui contrôlent l'évolution des populations par mutations discrètes, ce que l'on appelle la microévolution. A la suite de la découverte de la structure de l'ADN par James Watson et Francis Crick en 1953, de nouvelles recherches ont permis de confirmer le transformisme, d'établir des arbres phylogénétiques reliant les espèces en une classification générale du monde vivant. Ce qui caractérise le monde vivant c'est une grande unité de composition. Chez tous les organismes on trouve les mêmes éléments de base, acides aminés, ADN, ARN, protéines. Le code génétique est pratiquement le même dans tous les organismes, ce qui faisait dire à Jacques Monod que ce qui est vrai pour la bactérie est vrai pour l'éléphant. L'évolution et l'apparition de nouvelles espèces dépendraient alors des mutations et de nouvelles combinaisons de gènes ce qu'indiquaient déjà François Jacob (1920-2013) et Jacques Monod (1910-1976) (fig 66). Comme beaucoup de travaux de la génétique moléculaire montraient que les mêmes gènes existaient dans beaucoup d'espèces et que les mécanismes de leur expression étaient comparables cela entrainait corrélativement une nouvelle définition de l'espèce ce qu'indiquaient déjà Jacob et Monod dans un discours très déterministe : « L'espèce peut se concevoir comme la somme de tous les gènes contenus dans les individus qui la constitue ;l'apparition de nouveaux gènes par mutation, celle de nouveaux assortiments donnent naissance à des formes nouvelles d'où la sélection naturelle extrait des espèces nouvelles » F. Jacob, La logique du vivant, p 244. « Les évènements qui ouvrent la voie à l'évolution sont fortuits mais une fois inscrits dans l'ADN, l'accident singulier est fidèlement répliqué. : tiré du règne du pur hasard il entre dans celui de la nécessité » J.Monod, Le hasard et la nécessité, p 135.
Monsieur Leeuwenhoek, vous comprendrez que je ne peux souscrire aux conclusions de mes lointains disciples qui s'inscrivent dans la droite ligne du monisme des grecs anciens : pour eux la seule substance est la matière. La science est pour eux un empirisme objectif dont la règle est la reproductibilité. Pour moi l'explication mécaniste n'est valable que dans le domaine de l'inorganique mais non pour le vivant. Si ce dernier évolue, c'est selon un plan, un dessein intelligent, même si cela est mal vu, en un mot une complexification le conduisant vers ce point oméga dont parlait Teilhard de Chardin. Je vous retrouve bien là, Monsieur Pasteur, vous êtes encore un vitaliste spiritualiste de la vieille école. Mais depuis la fin du XXème siècle les choses ont bien changé, les biologistes ont compris que la biochimie mécaniste, qui est un peu votre fille, ne peut se passer de l'apport des naturalistes évolutionnistes adeptes de Darwin pour étudier les grands problèmes que pose la vie. Si les biochimistes expliquent le comment des phénomènes, les évolutionnistes expliquent le pourquoi. Ils s'allient pour expliquer. Voyez-vous, Pasteur et Darwin même combat !! Mais vous le savez aussi, Monsieur Pasteur, déjà à votre époque certains savants illustres pensaient comme certains anciens que la vie était apparue au sein de la matière organique, ce qui contredisait votre réfutation de la génération spontanée. Leeuwenhoek a raison Depuis que Wöhler avait réalisé la synthèse de l'urée, nombre de physiciens et biologistes pensaient que la vie avait pu naitre de la matière organique. Alternativement quelques-uns envisageaient un ensemencement depuis l'espace : Thomson, lord Kelvin et Svante Arrhenius étaient de ceux-là, acceptant la théorie de la Panspermie, la vie venue du cosmos. Mais cela ne faisait que reculer le problème de l'origine de la vie. En revanche, d'autres comme Haeckel ou Nägeli, proposaient une lente évolution de la matière minérale en matière organique puis en protoplasme, dernière étape avant la cellule. Mais au début du XXème siècle les connaissances nouvelles permettent la naissance de théories comme celle d'Oparine (The origin of life,1938) pour qui des systèmes échangeant matière et énergie avec leur milieu se seraient formés dans les océans primitifs : ils avaient un nom : "coacervats". Mais d'autres, comme Hermann Müller, soutenaient, à la suite de Troland, que des "sortes d'enzymes", nées dans la soupe primitive et s'entourant d'une sphère graisseuse d'origine colloïdale, auraient la propriété de croitre et de se multiplier. Pour Müller, ces "enzymes" ce sont les gènes. Un grand pas est franchi quand en 1950 Stanley Miller obtient des acides aminés et de l'acide cyanhydrique en soumettant à l'action d'un arc électrique un mélange de méthane, d'hydrogène, d'ammoniac et de vapeur d'eau bouillante. Or on connaissait déjà l'intérêt de l'acide cyanhydrique pour la formation de purines, des constituants des acides nucléiques. Finalement Carl Woese en 1967 propose que l'ARN qui peut présenter des propriétés catalytiques et autoréplicatives (ribozymes) soient à la base du vivant. Des polymères d'ARN seraient à l'origine d'un monde ARN déjà envisagé par Walter Gilbert en1986. Monsieur Leeuwenhoek, la vie engendre la vie et ce ne sont pas les théories d'Oparine et ses "coacervats", celle de Muller et ses gènes ou les polymères autoreproductibles d'ARN qui me feront changer d'avis. Quant à la double hélice de l'ADN, c'est un beau travail de physicien qui montre comment la vie donne naissance à la vie, ce que je soutiens depuis toujours. Je comprends, Monsieur Pasteur, et je respecte votre point de vue mais on ne peut faire abstraction des travaux de la fin du XXème siècle et des acquis de la génétique moléculaire qui montrent que, pour faire du nouveau, la nature dispose d'une sorte de mécano composé de pièces élémentaires, les gènes, à partir desquelles elle réalise toutes sortes de combinaisons. Cela évoque Kandinsky qui créait de nouveaux tableaux avec des motifs graphiques souvent analogues mais soumis à une nouvelle combinatoire. On peut dire avec François Jacob que la nature bricole et que l'évolution n'est que la succession de ces bricolages qui, apparus au hasard, ne survivent que s'ils sont viables. Etes-vous satisfaits d'apprendre que pour la nature vous n'êtes qu'une petite bricole, Monsieur Pasteur ? Leeuwenhoek a encore raison, l'évolution bricole Comme les néodarwinistes, on admettait que la macroévolution n'était que le développement avec le temps de la microévolution bien étudiée chez des organismes comme la drosophile. Pourtant, vers 1940, un généticien américain d'origine allemande, Richard Goldsmidt (1878-1958), avait suggéré que les espèces nouvelles se formaient selon un mécanisme différent. Il postulait l'existence de mutations affectant le programme de développement qu'il avait nommées "mutations systémiques". Elles donnaient naissance à des individus qu'il avait nommés monstres prometteurs d'évolution.


Fig 67 : E.Lewis Fig 68 : drosophile à 4 ailes
Ces sortes de monstres*, le généticien américain Edward Lewis (1918-2004, Nobel 1995, fig 67) en caractérise lorsqu'il montre que le développement de la mouche drosophile est sous la dépendance de gènes particuliers, baptisés du nom savant de gènes homéotiques, dont la mutation provoque l'apparition sur l'individu de structures normales en des endroits anormaux, par exemple une paire d'aile sur le 3ème segment thoracique de la mouche qui a alors 4 ailes (fig 68).Ces gènes homéotiques sont fortement conservés au cours de l'évolution.
*Dès la fin du XIXème siècle, bien avant la découverte des gènes homéotiques, on avait observé des anomalies morphologiques chez des coléoptères: par exemple une patte à la place d'une antenne (Bateson,1894).
Comme les gènes homéotiques, les gènes du développement embryonnaire sont fortement conservés au cours de l'évolution, ce qui fut bien démontré par Walter Ghering (1939-2014, fig 69), un embryologiste suisse, qui a étudié les mécanismes génétiques qui président à la formation de l'œil. Cette étude est particulièrement démonstrative du rôle des gènes dans la différenciation d'un organe.



Fig 69 : Walter Ghering Fig 70 : planaire Fig 71 : ascidies
Ghering et ses collaborateurs montrent qu'un certain gène (non-homéotique) baptisé Pax6 peut provoquer l'apparition d'yeux en position anormale en des endroits variés du corps (yeux ectopiques). Des mutations de ce gène provoquent des modifications de la forme de l'œil chez les vertébrés. Une variété du gène Pax6 de la souris (small eye), implanté dans le génome de drosophile donne un œil de drosophile et non de souris. Pax donne donc l'information pour la formation d'un œil mais pas pour sa construction, celle-ci dépend de milliers de gènes ouvriers de la drosophile. Or ce gène Pax6 se retrouve dans toutes sortes d'organismes : insectes, céphalopodes et même chez des vers plats (planaires, fig 70), des ascidies (fig 71) ou des méduses dans lesquels il règle l'apparition de zone sensible à la lumière. Les yeux des divers organismes sont donc formés sous l'effet d'un même gène pilote qui aurait une origine très ancienne. Ces gènes du développement embryonnaire, véritables gènes architectes, seraient à l'origine de la macroévolution. Ils dirigent l'expression de nombreux autres gènes dits ouvriers qui eux modifient des détails du plan et sont à l'origine de la microévolution. Au cours de l'évolution tous ces gènes, comme des pièces d'un immense mécano, sont l'objet de réarrangements structuraux et fonctionnels et sont utilisés dans des combinaisons différentes selon les organismes. Ainsi "bricole" la nature ! L'auteur reste dubitatif sur les propos suivants attribués à Pasteur. Monsieur Leeuwenhoek tout ce beau travail de génétique moléculaire ne règle rien, vos savants décrivent les phénomènes et les imputent à des gènes dont ils ignorent l'origine. Ils comprennent le fonctionnement de l'horloge et les raisons de sa conception mais ils n'en connaissent toujours pas le constructeur. Pour eux l'horloge s'est construite toute seule, ce que pensaient déjà des encyclopédistes. Et pour le prouver ils n'ont que des théories. Tous ces scientifiques devraient se souvenir de ce que j'ai dit : « Un peu de science éloigne de Dieu, mais beaucoup y ramène » Mais, Monsieur Pasteur, cette auto-construction de la vie que prône la biologie moderne n'est- elle pas comparable au Big-Bang des physiciens : le monde, la matière et le temps surgis de rien. Et souvenez-vous que dans une allocution à l'Académie Pontificale des Sciences le pape François indique, en octobre 2014, que « le Big Bang, qui est aujourd'hui considéré comme les origines du monde, n'est pas en contradiction avec l'intervention créative de Dieu, au contraire, il la nécessite » et il poursuit en expliquant que « l'évolution dans la nature n'est pas incompatible avec la notion de création » . D'ailleurs les livres sacrés eux-mêmes n'impliquent-t-ils pas aussi une sorte de Big-Bang initial ?

Fig 72 : Paul Signac, la salle à manger. Ce pourrait être la fin du diner de Pasteur !
C'est là une intéressante question Monsieur Leeuwenhoek, elle fera encore couler beaucoup d'encre et de salive..Mais voyez-vous Madame Pasteur m'attend, elle aura préparé le souper que nous prendrons ce soir comme on en avait l'habitude, jadis dans notre appartement, à l'Institut car voyez-vous, Monsieur Leeuwenhoek, si au-delà de la voûte étoilée, il y a de nouveaux cieux étoilés et, au-delà, d'autres encore! Alors l'éternité, voyez-vous, ce n'est pas l'évolution mais l'infinie complexité de l'univers et sa fixité ce que pensait déjà Einstein en ajoutant la constante cosmologique dans ses équations...Ah, Monsieur Leeuwenhoek, je vous salue bien, j'ai été ravi de faire votre connaissance et, malgré nos petits accrochages, j'ai tout à fait apprécié notre petite conversation. Bonsoir, Monsieur Pasteur, bonne soirée et bon souper...et présenter mes hommages à Madame Pasteur... Mais Pasteur s'était déjà éloigné en claudiquant un peu. Pasteur et Leeuwenhoek pourront encore disserter sur la genèse et l'évolution de la vie au cours de leurs rencontres futures. Mais, malgré leurs divergences probables, ils seront au moins d'accord pour admirer La genèse (1508-1512) de Michel-Ange à la chapelle sixtine vaticane. L'œuvre est immense par sa qualité esthétique mais aussi parce qu'elle est le fruit du travail de l'artisan perché pendant quatre années sur son échafaudage pour la peindre. Je vous remercie de votre attention.

Fig 73 : Michel-Ange, La genèse.
J-R 09-2024